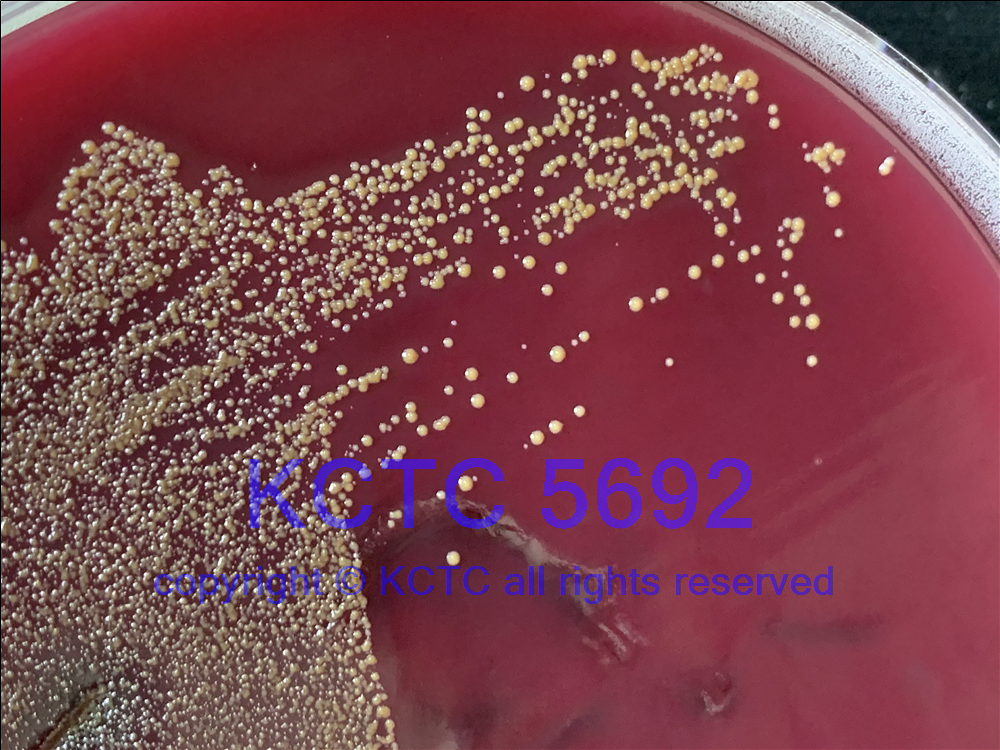

KCTC No. 15075
(KCTC Other No.)
Resource Type Bacteria
Name Hoylesella nanceiensis
Type Strain Yes
Biosafty Level 2
LMO No
Synonym Prevotella nanceiensis
Phylum (ex Phylum) Bacteroidota (Bacteroidetes)
Genome Information
NCBI Genome UID : GCA_000379965.1
JGI Genome ID : Gp0013163
History <- JCM <- CCUG <- CIP <- JP Carlier, AIP 261.03 <- F Mory, LBN 293
Source From human blood culture from a 78-year-old man, Nancy, France
Other Collection No. AIP 261.03, LBN 293, CCUG [54409], CIP [108993], DSM [19126], JCM [15639]
Reference 10.1099/ijs.0.65173-0, 10.1016/j.syapm.2022.126354, 10.1099/ijsem.0.005709
KCTC Media No. KCTC media No. 293 EG Medium
Oxygen Requirement Anaerobic
Temperature 37 ℃
pH netural pH ?? ?? (???? ??)
Incubation Time 3-4 d [???? ???? ????? ??, ?? ? ????? ??? ?? ?? ? ??]